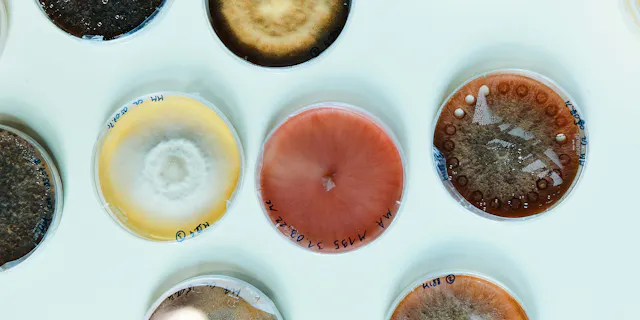

Creating platforms for productivity
Interview with Fiona Marshall, President Novartis Biomedical Research.

Stronger together
Team spirit.

The power of collaboration
Talking is golden.

Helping people solve problems
Don't let others define you.

Resilience rules
Editorial by Steffen Lang for Live N°13.

Science, serendipity and a strong sense of patient needs
A conversation with Shiva Malek.

Innovation requires courage
Editorial by Joerg Reinhardt for Live N°12.

The future of medicine is here
The promise and challenges of medicine.

Broadening the spectrum
Op-ed by Vas Narasimhan.

Collective strength
Bringing academia and industry together.
Courage and collaboration
Editorial by Joerg Reinhardt.

«We seek an active dialogue with society»
A conversation with Joerg Reinhardt.

A platform for intellectual exchange
Editorial by Matthias Leuenberger.

Innovation and collaboration
Editorial by Matthias Leuenberger

Doing the right thing
Key lessons.

Courage and confidence
Editorial by Joerg Reinhardt.

«We need to put the patient at the center of our environmental considerations»
Pushing for a holistic environmental approach.

«We have to include the developing world in the innovation cycle»
Developing access.

«We need to think big to tackle climate change»
Know-how from the Pentagon.

Passion for data
1:1 with Chief Digital Officer Bertrand Bodson.
Shorts
Our stories in shortform

Browse back issues
Download past issues of liv magazine.
Access to downloadable PDFs
Live Magazine – Science, made human
Discover the story behind Live Magazine, Novartis’ global publication launched in 1996 and now available in four languages. Explore how it evolved into a digital platform in 2020, sharing insights and innovations from across the company.
Learn more
About live magazine
Live magazine has been the in-house magazine of Novartis since 1996. It is available to the general public since 2020.
Associates/Pensioners
Associates in Switzerland and pensioners can receive the Forum supplement with birthday and other data via email. Please write to live.magazine@novartis.com, providing your name and personnel number.
Get our Updates
Stay connected by subscribing to our newsletter
By submitting your email, you consent to Novartis AG collecting and processing your email data for Novartis internal use, in accordance with our privacy policy, and by protected technical means.






























